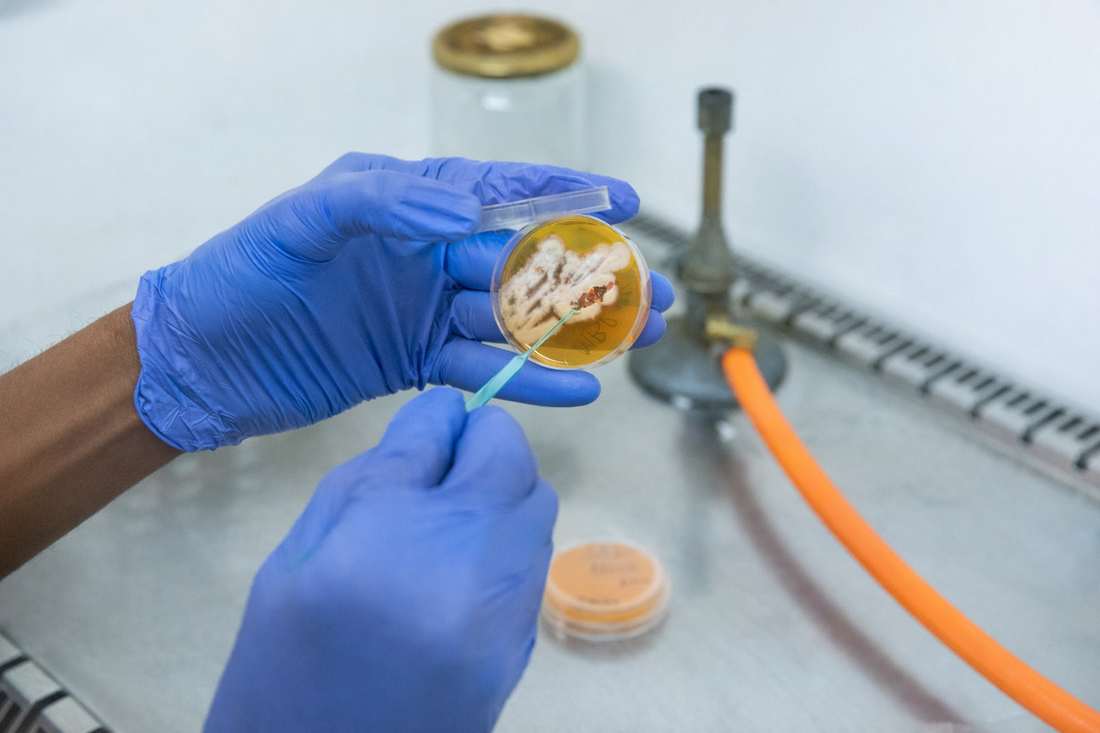
Rufin 2

Kamerunský mikrobiolog Rufin Marie Toghueo Kouipou působí v rámci programu MERIT Středočeského inovačního centra v Mikrobiologickém ústavu Akademie věd ČR a v centru BIOCEV. V rozhovoru mluví o svém výzkumu v jednom z nejnaléhavějších témat současné medicíny – antibiotické rezistenci a nových léčivech, i tom, co ho přivedlo do Česka.
V rámci svého výzkumu se věnujete antibiotické rezistenci. Proč je to celosvětové téma?
Antibiotická rezistence je skutečně globální problém. Každý rok o ní vychází statistiky, které ukazují, jak roste počet lidí, kteří umírají na infekce způsobené bakteriemi odolnými vůči dostupným lékům. Rezistence nezná hranice – týká se rozvojových zemí i těch nejvyspělejších. Právě to mě vede k otázce, odkud mohou přijít nové účinné látky.
Moje strategie je jednoduchá, i když vědecky náročná: vydat se tam, kam se zatím příliš nechodí, a hledat mikroorganismy v extrémních nebo špatně prozkoumaných prostředích. Většina antibiotik, která dnes používáme, vznikla právě díky mikroorganismům. Je tedy logické předpokládat, že v neprobádaných ekologických nikách mohou existovat organismy, které produkují nové, dosud neznámé látky.
Proto jsem v Kamerunu odebral velké množství vzorků z různých prostředí. V laboratoři je pak analyzuji dvěma způsoby: metabolomikou, která ukazuje, jaké látky mikroorganismy produkují, a genomikou, která odhaluje, jaké biosyntetické dráhy mají k dispozici. Tyto přístupy se navzájem doplňují a společně umožňují identifikovat organismy či látky s potenciálem stát se základem pro nový lék.
Co vás osobně přivedlo k tématu antibiotické rezistence?
Během doktorského studia v Kamerunu jsem pracoval s mikroorganismy, konkrétně s houbami žijícími v symbióze s rostlinami. Díky výzkumným pobytům v Indii a Španělsku jsem měl možnost poznat různé vědecké přístupy a zároveň získat potřebný nadhled.
Uvědomil jsem si dvě věci. Zaprvé, že výzkum antibiotické rezistence je vědecky nesmírně fascinující – je to výzva, která vás nutí neustále přemýšlet a hledat nové cesty. A zadruhé, že má obrovský společenský význam. Nevytváříte abstraktní poznání, ale něco, co může přímo zachraňovat životy.
Když se objevil program MERIT, nebyl jsem si jistý, zda se můj projekt vůbec bude do výzvy hodit. Konzultoval jsem to s koordinátory programu i s mým nynějším supervizorem v Mikrobiologickém ústavu AV ČR. Jejich podpora mě povzbudila a nakonec jsem se přihlásil – úspěšně.
A přiznám se, že to pro mě znamenalo i rozhodnutí mezi několika velmi prestižními možnostmi. Měl jsem nabídku z Brazílie a také stipendium JSPS (pozn.: Japan Society for the Promotion of Science) do Japonska. Přesto jsem si vybral Českou republiku.

Co byste si přál zvládnout během 30 měsíců trvání grantu? Přece jen vývoj nového antibiotika je běh na dlouhou trať.
To rozhodně je. Objevování nových antibiotik není disciplína, kterou lze dokončit za rok nebo dva. Přesto doufám, že během této doby dosáhnu alespoň jednoho konkrétního, slibného výsledku, který se stane základem pro další výzkum – například ve spolupráci s průmyslem.
Ten výsledek může mít podobu nové molekuly, kterou bude možné chemicky upravit a testovat jako kandidáta na nový lék. Nebo to může být samotný mikroorganismus, který tuto látku produkuje. Obě varianty mají velkou hodnotu. Mikroorganismy lze totiž dále upravovat tak, aby látku produkovaly ve větším množství nebo v účinnější podobě. A pokud objevíte jeden opravdu zajímavý organismus, často to naznačuje, že v daném prostředí mohou být i další.
Takový projekt je typickým příkladem toho, čemu se říká „high risk, high reward“. Dlouho nemusíte najít vůbec nic – ale pokud narazíte na jeden dobrý výsledek, může to znamenat průlom.
Už i děti znají pojem antibiotická rezistence
Jak vážný je podle vás problém antibiotické rezistence?
Je to velmi vážná hrozba. A je globální. Existuje mnoho vědeckých směrů, jak problém řešit: epidemiologie, molekulární biologie, genomika, vývoj nové diagnostiky… Já se zaměřuji na objevování nových látek, ale to je jen jeden dílek z mnoha. Každý přístup má svoje místo.
V rámci svého výzkumu testuji, jak nové látky působí na nejodolnější bakterie, které máme v laboratoři. Je to strategická volba – pokud se látka dokáže prosadit u těchto „nejhorších“ mikroorganismů, je šance, že bude klinicky relevantní.
Jak podle vás vypadá současný vývoj v oblasti antibiotické rezistence?
Vidím v něm několik zajímavých posunů. Jedním z nich je rozhodně rostoucí financování. Za posledních pět let se výrazně zvýšil počet grantů, které se tomuto tématu věnují. Antimikrobiální rezistence se dostala do centra pozornosti politických reprezentací, velkých nadací i neziskových organizací. A to je zásadní, protože bez financí se věda nepohne dopředu.
Druhou oblastí je rychlý technologický rozvoj. Moderní genomika, která nebyla před deseti lety zdaleka tak dostupná jako dnes, nám nyní umožňuje sledovat geny rezistence v reálném čase, mapovat šíření rezistentních kmenů a rychle testovat účinnost nových látek. To vše zrychluje a zkvalitňuje výzkum.
Změnilo se ale i něco dalšího – společenské povědomí. Ještě před pár lety nešlo téma antibiotické rezistence běžně slyšet v médiích. Teď, třeba i děti, které chodí na akce k nám do Mikrobiologického ústavu AV ČR, už ví, co tento pojem znamená. A to je možná větší průlom, než se zdá. Pokud veřejnost chápe naléhavost problému, reagují na něj i politici, kteří rozhodují o tom, kam půjde financování výzkumu.
Co jsou dnes největší překážky výzkumu antibiotické rezistence?
Těch překážek je několik. Jedna z nejvýraznějších leží mimo samotnou vědu – jde o politicko-regulační prostředí, které určují státní instituce. Mezi tím, co vědci dělají v laboratoři, a tím, jaké byrokratické procesy a regulace musí dodržovat, někdy existuje obrovská propast. Vývoj nového léku může trvat patnáct až třicet let a je zatížen množstvím administrativy, která často neodpovídá tomu, jak urgentní problém vlastně řešíme. Je to struktura, která věci výrazně zpomaluje.
Druhou skupinou překážek je samotná biologie mikroorganismů. Bakterie mají neuvěřitelnou schopnost přizpůsobit se a vyvíjet nové mechanismy rezistence. I když o tomto procesu víme mnoho, stále existují oblasti, kterým plně nerozumíme. V okamžiku, kdy se snažíte najít nový lék, narazíte na to, že organismus, který jste chtěli „porazit“, si mezitím našel jiný způsob, jak se bránit. A to je vědecky i technologicky značná výzva.

Program MERIT nabízí skutečné zázemí pro dlouhodobý projekt
Říkal jste, že jste měl vedle programu MERIT několik dalších nabídek. Čím vás tedy MERIT zaujal natolik, že jste dal přednost právě České republice?
Největší rozdíl byl v tom, že MERIT nabízí skutečné zázemí pro dlouhodobý projekt. V postdoktorské kariéře je totiž největším problémem neustálý kolotoč krátkodobých smluv. Často dostanete rok nebo dva, dokončíte část práce – a pak musíte začít znovu. Nový grant, nové místo, nový tým. Je to náročné nejen profesně, ale i lidsky.
MERIT je v tomhle jiný. Dává možnost projekt opravdu rozvíjet a také vytváří prostor pro to, aby mohl pokračovat dál. Můj současný supervizor, Zdeněk Kameník, má podobný způsob uvažování. Oba víme, že vývoj nové bioaktivní molekuly nemůže být hotový za 30 měsíců. Proto už teď plánujeme další kroky a hledáme navazující financování.
MERIT mi tak nabídl nejen finanční podporu, ale i něco mnohem důležitějšího: perspektivu. A právě ta rozhodla oproti i třeba prestižnějším možnostem.
Jaké máte z českého vědeckého prostředí dojmy? Přeci jen jste působil v několika zemích – vidíte rozdíly?
Ano, několik. A většinou pozitivních.
V první řadě mě překvapila velmi silná orientace na kvalitu vědy samotné. V některých zemích je akademická hierarchie výrazná a názor postdoka nebo mladého výzkumníka není vždy vnímán jako rovnocenný. V Mikrobiologickém ústavu AV ČR jsem ale zažil pravý opak. Nezáleží na tom, zda jste student, postdok nebo profesor – pokud máte dobrý nápad nebo relevantní argument, jednoduše ho předložíte. To je nesmírně osvobozující a motivující.
Druhá věc je otevřenost vědecké komunity. Na institutu se neustále konají semináře, prezentace, interní setkání. Ale kromě nich mě překvapilo, jak snadné je zajít do vedlejší laboratoře, zeptat se na radu, půjčit si přístroj nebo jednoduše probrat problém s někým, kdo se dívá na věc jinak. V jiných institucích, kde jsem pracoval, to vůbec nebývalo samozřejmostí.
Tato otevřenost sdílení způsobuje, že se znalosti i zkušenosti „pohybují“ a vy se učíte mnohem rychleji. Pro ambiciózní projekt, jako je vývoj antibakteriálních molekul, je to obrovská výhoda.
Setkal jste se naopak i s nějakými překážkami? Ať už vědeckými nebo kulturními?
Vědecky mohu říct, že je moje zkušenost opravdu dobrá. To ale neznamená, že vše bylo od počátku snadné. Určitým problémem je jazyková bariéra. Ne všichni v Česku se domluví anglicky a pro cizince to může být někdy složitější při komunikaci v běžném životě.
A pak je tu téma, které není lehké, ale myslím si, že je správné o něm mluvit otevřeně. Několikrát jsem se setkal s rasistickým chováním. Nebylo to časté, ale stalo se to – jednou dokonce velmi výrazně. Nebyl to příjemný zážitek. Co pro mě ale bylo velmi důležité, byla reakce lidí v mém pracovním okolí. Když jsem situaci sdílel se svými kolegy, reagovali s velkou empatií a podporou, což hodně pomohlo.
Myslím, že pro každého, kdo přijde pracovat do nové země, je důležité, aby měl pocit, že o věcech může mluvit otevřeně. A já mám štěstí, že takové prostředí v laboratoři mám.
A jaké kulturní rozdíly vás v Česku nejvíce překvapily?
Nebudu asi originální, ale Česká republika je pro mě zemí, kde lidé působí na první pohled poněkud rezervovaně. Nejsou to lidé, kteří by vás hned objali nebo se s vámi zapovídali na ulici. Mohou působit chladně nebo uzavřeně.
Na druhou stranu – a to musím zdůraznit – si velmi cením české přímočarosti. Když Češi něco myslí, obvykle to i řeknou. Nemají tendenci skrývat nesouhlas nebo nepříjemné sdělení za zdvořilou fasádu. V Česku obvykle poznáte skutečný názor hned. A mně osobně to vyhovuje. Usnadňuje to komunikaci a zjednodušuje život.
Pojďme se ještě dotknout spolupráce s průmyslem, protože antibiotická rezistence je oblast, kde se potenciálně prolíná akademie a aplikovaný výzkum. Jak podle vás funguje spolupráce mezi soukromým a akademickým sektorem?
Zatím jsem osobně v téhle fázi výzkumu ještě nebyl, ale z toho, co vidím ve svém oboru, je zřejmé, že spolupráce mezi akademickou sférou a průmyslem v oblasti antibiotik většinou nevzniká na základě článku nebo zajímavé myšlenky. Průmysl potřebuje konkrétní výsledek: molekulu, metodu, test, něco, co má praktický potenciál. Jakmile výzkumník takový výstup má, věci se začnou hýbat rychleji. Najednou se o projekt začnou zajímat firmy, investoři nebo nadace.
Existuje však i jiný typ spolupráce: outsourcing. V některých případech je mnohem výhodnější nechat určité analýzy provést externí firmou, která má specializované vybavení a procesy. Když víte, že by vám konkrétní test v akademických podmínkách trval půl roku, zatímco firma ho zvládne za týden, je to logické rozhodnutí. Šetří to čas, peníze i energii.
V budoucnu se samozřejmě rád dostanu do bodu, kdy bude možné začít o spolupráci s průmyslem reálně uvažovat. A právě MERIT mi dává prostor vytvořit si takový základ, který může do této fáze vést.

Když se podíváte trochu do budoucnosti – kam byste chtěl svůj výzkum posunout?
Můj cíl je jednoduchý a zároveň dlouhodobý: rád bych, aby projekt nezůstal jen na akademické úrovni. Objevování nových antibiotik je samozřejmě maraton, nikoliv sprint. Vyžaduje roky práce, opakovaná testování a také velké dávky trpělivosti.
Pokud se mi podaří identifikovat mikroorganismus nebo látku s reálným potenciálem, byl by to začátek cesty, která by mohla vést až k praktické aplikaci. A to je pro mě osobně velmi silná motivace.
Také bych rád, aby výzkum mohl jednou přispět i regionům, odkud pocházím. Kamerun a vůbec mnoho částí Afriky je plných ekologických prostředí, která zatím téměř nikdo neprozkoumal. Věřím, že tam může být ukryto mnoho bioaktivních látek, které čekají na objevení. Kdyby se někdy podařilo propojit výzkum tady v Česku s potenciálem těchto prostředí, bylo by to pro mě velké osobní naplnění.
Rozhovor vznikl v rámci copywritingové spolupráce, která má za cíl představit program MERIT Středočeského inovačního centra.
Foto: Gabriela Goffová
Rufin Toghueo je kamerunský výzkumník, který se zaměřuje na boj s infekčními onemocněními prostřednictvím výzkumu mikrobiální biodiverzity Afriky a hledání nových terapeutických možností. Soustředí se na objevování léčiv z přírodních zdrojů, zejména na identifikaci bioaktivních látek produkovaných aktinobakteriemi, jež mohou působit proti bakteriím rezistentním vůči antibiotikům. Vedle vlastního výzkumu se věnuje také pedagogickému a mentorskému působení. Zasazuje se o podporu nastupující generace afrických vědců, a to prostřednictvím rozvoje vůdčích dovedností, multidisciplinárního přístupu k výzkumu a důrazu na vysokou úroveň vědecké práce.
- Autor článku: ano
- Zdroj: VědaVýzkum.cz pro SIC
